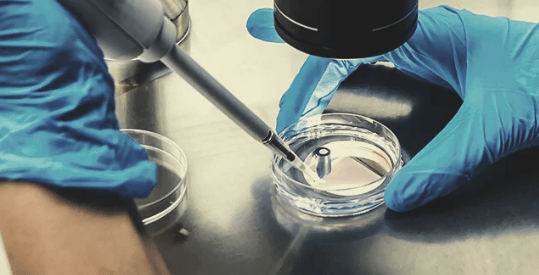
1683210323460.png 1683210323460.png

- 24 Апр 2020
- 7,122
- 14,551
- 160
-

- 6
Доктор Рафаэль Мешулам – первооткрыватель и исследователь ТГК
История взаимодействия человека с коноплей насчитывает тысячелетия. В древних цивилизациях ее считали универсальным источником пользы: из стеблей плели прочные канаты, ткали ткань для одежды, из семян готовили пищу, а в религиозных обрядах растение использовали как символ связи с природой и духовным миром. Но все это были практические и ритуальные стороны применения. Настоящая тайна конопли начала раскрываться лишь в XX веке, когда в руки исследователей попали современные методы химического анализа. Тогда-то и стало ясно, что за привычным растением скрывается сложнейший набор биологически активных веществ, которые взаимодействуют с организмом человека особым образом.За это открытие современное общество обязано не одной личности, но именно Рафаэль Мешулам стал человеком, чьи исследования перевернули представления о каннабисе. Он первым выделил тетрагидроканнабинол — соединение, которое определяет уникальные свойства растения. Но на этом ученый не остановился. Его работы стали ключевыми для понимания эндоканнабиноидной системы, которая регулирует множество процессов в организме, включая настроение, память, аппетит и реакцию на стресс.
Мешулам не просто занимался лабораторной наукой. Его исследования дали практический результат. Благодаря им в медицине появились новые подходы к лечению хронической боли, эпилепсии, аутоиммунных заболеваний и других тяжелых состояний. Научное сообщество и пациенты по всему миру признали его заслуги, а коллеги называли его с уважением, но и с теплом — «Рафи». Свою карьеру он посвятил каннабису без остатка, и она длилась более шести десятилетий. В 1990-е годы он стал одним из основателей Международного общества исследования каннабиноидов (ICRS), которое объединяет специалистов разных направлений. Это сообщество и сегодня продолжает его дело, развивая медицину будущего.
Весной 2023 года Рафаэля Мешулама не стало. Однако его наследие невозможно измерить лишь научными публикациями. Оно живет в тысячах пациентов, которым его открытия помогли справиться с тяжелыми диагнозами, в молодых ученых, вдохновленных его работами, и в самой науке, сделавшей благодаря ему гигантский шаг вперед. Многие исследователи сравнивают его вклад с работами Пастера или Флеминга, ведь именно Мешулам показал, что в каннабисе скрыт целый мир, достойный глубокого изучения.
Мешулам и его недавнее открытие
Рафаэль Мешулам всегда считался человеком, который умел находить научные пробелы и превращать их в открытия. Его имя прочно связано с выявлением и описанием тетрагидроканнабинола, а также с определением роли эндоканнабиноидной системы в организме человека. Но примечательно, что даже спустя десятилетия после этих ключевых достижений он не остановился. В 2020 году, когда ученому исполнилось девяносто лет, он представил миру новое открытие, доказав, что настоящая наука не имеет возраста.Вместе с коллегами Мешулам смог сделать то, что считалось практически невозможным: стабилизировать крайне нестойкие соединения, известные как каннабиноидные кислоты. Эти вещества, хотя и считались перспективными для медицины, десятилетиями оставались за пределами практических исследований именно из-за своей хрупкой структуры. Попытки фармацевтов работать с ними регулярно заканчивались неудачами: соединения теряли свойства еще на этапе хранения. Мешулам предложил решение, создав новое стабильное производное — соединение, известное сегодня под названием EPM301. Его появление стало переломным моментом для науки о каннабисе, ведь оно впервые дало исследователям в руки инструмент, позволяющий системно изучать кислоты и их взаимодействие с организмом.
Это открытие особенно символично, ведь в то время как многие ученые к концу карьеры подводят итоги, Мешулам сумел открыть новую страницу исследований. Его работа стала не только итогом шестидесятилетнего рабочего пути, но и началом нового этапа, который в перспективе может привести к созданию лекарств с уникальными свойствами.
Что такое каннабиноидные кислоты?
Каннабиноидные кислоты — это соединения, которые в естественных условиях синтезируются в железистых трихомах конопли. Эти микроскопические образования покрывают поверхность соцветий блестящим «инеем» и являются источником основных биологически активных веществ растения.
В свежем виде каннабис почти не содержит привычных каннабиноидов вроде ТГК или КБД. Вместо этого в нем преобладают их кислотные предшественники: тетрагидроканнабиноловая кислота (ТГКк), каннабидиоловая кислота (КБДк) и другие. Их структура отличается от активных форм наличием карбоксильной группы, которая определяет их свойства и делает их отдельным классом соединений.
Для рекреационного использования растение обычно подвергается нагреванию — процессу, известному как декарбоксилирование. При этом кислоты теряют карбоксильную группу и превращаются в привычные активные формы, такие как ТГК или КБД, которые и вызывают психоактивный или расслабляющий эффект. Именно поэтому люди, ищущие удовольствие, нагревают каннабис, чтобы получить выраженное действие.
Тем не менее ученые давно подозревали, что кислотные формы каннабиноидов могут быть не менее ценными, чем их производные. Исследования последних лет указывают, что кислоты способны влиять на иммунный ответ, оказывать противовоспалительное действие, воздействовать на пищеварительные процессы и даже замедлять развитие некоторых дегенеративных заболеваний. Особый интерес вызывает каннабидиоловая кислота (КБДк), которая в ряде случаев проявляет более выраженные эффекты, чем сам КБД.
Однако все эти свойства до недавнего времени оставались в большей степени теоретическими. Нестабильность кислот делала невозможным их использование в медицинской практике и сильно ограничивала исследования. По сути, перед учеными стояла классическая дилемма: вещество обладает огромным потенциалом, но технически его невозможно изучать или применять. И решение этой проблемы и стало последним большим вкладом Мешулама.
EPM301 и КБДк
На протяжении всей карьеры Рафаэль Мешулам сотрудничал с различными лабораториями и исследовательскими группами, всегда оставаясь на передовой каннабиноидной науки. В последние годы он присоединился к команде EPM — фармацевтической компании, ориентированной на разработку новых терапевтических решений на основе синтетических производных каннабиноидов. В отличие от многих других игроков отрасли, сосредоточившихся на традиционных соединениях вроде ТГК и КБД, EPM сделала ставку именно на кислые формы — те самые нестабильные молекулы, которые в природе синтезирует растение.Генеральный директор компании Решеф Свиса подчеркивал: «Большинство индустрии работает с веществами, которые появляются уже после декарбоксилирования. Но нас больше интересует то, что изначально синтезирует сама конопля». По его словам, фармацевтические корпорации обычно обходят стороной исследования в этой области: природные молекулы невозможно запатентовать, а их нестабильность превращает любые попытки в рискованное предприятие. Именно поэтому участие Мешулама стало решающим фактором — он был единственным ученым, кто мог предложить практическое решение.
Проблема заключалась в том, что каннабиноидные кислоты буквально «тают» под воздействием света, тепла или даже просто при хранении. Для индустрии это означало, что перспективное направление исследований оставалось заблокированным. Мешулам сумел преодолеть это ограничение, применив химическую модификацию, известную как этерификация. Суть метода в том, что к молекуле каннабидиоловой кислоты (КБДк) присоединяется дополнительная группа, удерживающая карбоксильный фрагмент. Благодаря этому кислота сохраняет свою структуру даже в условиях, при которых раньше разрушалась.
Результатом стало новое стабильное соединение — метиловый эфир каннабидиоловой кислоты, или EPM301. Это вещество выступило своеобразным компромиссом между природой и химией: оно сохраняет уникальные свойства КБДк, но при этом достаточно устойчиво для промышленного производства и медицинских исследований.
EPM301 и возможности его использования
Создание EPM301 стало важным шагом в развитии медицины на основе каннабиноидов. Это соединение открыло возможность работать с каннабидиоловой кислотой (КБДк) в форме, пригодной для фармацевтических разработок, и сразу же вызвало интерес исследовательских центров и компаний по всему миру.Научные данные указывают, что EPM301 может оказывать более выраженное противовоспалительное и нейропротекторное действие по сравнению с традиционным КБД. В связи с этим основной фокус исследований сегодня сосредоточен на таких направлениях:
- Неврология. Изучается потенциал EPM301 при эпилептических расстройствах, включая синдром Драве, а также при нейропатической боли и нейродегенеративных заболеваниях. Ученые надеются, что соединение сможет регулировать электрическую активность мозга и защищать нервные клетки;
- Иммунология и воспалительные процессы. EPM301 рассматривается как перспективный агент для терапии хронических воспалительных заболеваний, включая аутоиммунные состояния. Его воздействие на иммунный ответ может открыть новые пути лечения таких болезней, как ревматоидный артрит или воспалительные заболевания кишечника;
- Гастроэнтерология. Есть основания полагать, что соединение способно снижать тошноту, улучшать аппетит и поддерживать работу ЖКТ, что делает его потенциально полезным в онкологии и паллиативной медицине;
- Психическое здоровье. Первые исследования намекают на возможное мягкое стабилизирующее действие EPM301 на настроение и уровень тревожности. В будущем это направление может стать альтернативой или дополнением к существующим антидепрессантам.
Перспективы EPM301 оцениваются очень высоко. Если предварительные данные подтвердятся в масштабных клинических испытаниях, в ближайшие годы мы можем увидеть целую линейку препаратов нового поколения, основанных на этом соединении. Для пациентов это может означать доступ к более эффективным и безопасным методам лечения, а для науки — переход к новой главе в изучении каннабиноидов.
Мешулам – отец исследований каннабиса
Открытие стабильных каннабиноидных кислот и создание EPM301 стало лишь одной из вех в жизни Рафаэля Мешулама. Его научный путь охватывает десятилетия и включает в себя целую серию фундаментальных открытий, каждое из которых открыло новую страницу в изучении каннабиса. От первых лабораторных экспериментов и выделения ключевых соединений до формирования целой научной школы и международных сообществ — все это результат его настойчивости и гениальности.
Начало исследований
Рафаэль Мешулам появился на свет в Болгарии в 1930 году, но в 1949 году его семья эмигрировала в Израиль, где для него начался новый жизненный и академический этап. Уже в студенческие годы стало ясно, что его будущее связано с химией. В 1952 году он получил степень магистра биохимии в Еврейском университете в Иерусалиме, а затем продолжил обучение в Институте Вейцмана в Реховоте, где защитил докторскую диссертацию по химии.Интерес Мешулама к органической химии и его стремление исследовать неизвестное постепенно вывели его к теме каннабиса — области, которая в те годы оставалась практически неизученной и воспринималась скорее как экзотика, чем как серьезный объект науки. В начале 1960-х годов вокруг этого растения существовало множество мифов и домыслов, но достоверных данных о его составе и свойствах почти не было. Мешулам поставил себе задачу изменить эту ситуацию. Среди коллег и по сей день вспоминают почти анекдотический эпизод, ставший отправной точкой его исследований, когда ученый сумел получить для работы несколько килограммов гашиша, изъятого израильской полицией. Этот случай обеспечил его лабораторию редчайшим по тем временам материалом и открыл путь к первым фундаментальным анализам химической структуры каннабиса.
В 1963 году команда под руководством Мешулама совершила важнейшее открытие. Они впервые описали химическую структуру каннабидиола (КБД). Это стало отправной точкой для системного изучения каннабиноидов. Более того, исследователи начали понимать, что эти вещества построены из повторяющихся «кирпичиков» — органических фрагментов, которые можно выделять, классифицировать и изучать по отдельности.
Открытие и синтез ТГК
После первых успехов с выделением КБД путь к следующему крупному открытию оказался удивительно коротким. Совсем скоро Рафаэль Мешулам вместе со своим коллегой Йехиэлем Гаони смогли выделить главный психоактивный компонент каннабиса — тетрагидроканнабинол (ТГК). Для этого они использовали тот же гашиш, полученный ранее от полиции, но теперь внимание ученых было сосредоточено на поиске вещества, которое определяет характерное воздействие растения на человека.В 1964 году они опубликовали работу под названием «Выделение, структура и частичный синтез активного компонента гашиша». Этот документ стал поворотным моментом в истории науки о каннабисе: впервые было представлено полное описание химической структуры ТГК, а также показан метод его синтеза. По сути, Мешулам и его команда не только идентифицировали активное соединение, но и доказали, что психоактивное действие каннабиса можно объяснить конкретной молекулой, а не расплывчатыми «растительными свойствами», о которых говорили десятилетиями.
Это открытие сделало Мешулама одним из ведущих исследователей своего времени. Но работа не остановилась на ТГК. В последующие годы его лаборатория продолжила систематическое изучение каннабиноидов и смогла описать химические структуры целого ряда других соединений, включая каннабигерол (КБГ), каннабициклол (КБХ) и несколько каннабиноидных кислот. Каждый новый шаг расширял представление о том, насколько сложен и разнообразен химический мир каннабиса.
Открытие эндоканнабиноидной системы (ЭКС)
После открытия ТГК различные исследования на животных и людях подтвердили, что он действительно является основным психотропным компонентом каннабиса. Однако ученые не знали, как каннабиноиду удается вызывать такой эффект, как он взаимодействует с человеческим организмом. Они знали о липофильной природе ТГК — о том, что каннабиноиды легко связываются с жиром, растворяясь в нем. Но как он воздействует на сознание было тайной.Именно этот поиск привел к одному из важнейших открытий второй половины XX века — обнаружению эндоканнабиноидной системы. В 1980-е и 1990-е годы исследования под руководством Мешулама показали, что в организме человека и животных существует целая сеть рецепторов, специально воспринимающих каннабиноидные соединения. Эти рецепторы получили название CB1 и CB2.
CB1-рецепторы оказались сосредоточены преимущественно в головном мозге и центральной нервной системе, где они влияют на настроение, память, аппетит и восприятие боли. CB2-рецепторы в основном локализованы в иммунной системе и отвечают за регуляцию воспалительных процессов. Таким образом, стало ясно, что каннабиноиды взаимодействуют с организмом через сложный биологический механизм, а не действуют хаотично, как предполагалось раньше.
Следующим шагом стало открытие того, что организм сам вырабатывает собственные каннабиноидоподобные вещества — эндоканнабиноиды. Одним из первых был идентифицирован анандамид, название которого происходит от санскритского слова ананда, которое можно перевести как «блаженство». Это открытие стало убедительным доказательством того, что каннабиноидная система — не внешнее влияние растения, а фундаментальная часть физиологии человека. И работы Мешулама в этой области стали основой для целой ветви медицины. Эндоканнабиноидная система сегодня рассматривается как ключевой регулятор гомеостаза, влияющий практически на все — от сна и аппетита до иммунных реакций и нейропротекции. Благодаря этому открытию наука получила не только объяснение действия каннабиса, но и новый инструмент для разработки лекарственных средств.
Легендарная фигура в науке о каннабисе
Имя Рафаэля Мешулама навсегда вписано в историю науки о каннабисе. Его открытия позволили не только раскрыть тайны самого растения, но и лучше понять человеческий организм, открыв целую систему, о существовании которой раньше никто не подозревал. Он стал ученым, которому обязаны и медицина, и миллионы пациентов, получивших шанс на новые методы лечения.За свою карьеру Мешулам удостоился множества научных наград и вошел в число 1% самых цитируемых исследователей в мире в своей области. Его статьи стали фундаментом для тысяч последующих публикаций, а идеи продолжают вдохновлять новые поколения ученых. В интервью BioMed Central в 2020 году, когда ему было уже девяносто лет, Мешулам поделился своим видением будущего. Он говорил о необходимости расширять клинические исследования, особенно в области онкологии, а также глубже изучать эндоканнабиноидную систему — ключ к пониманию множества процессов в организме человека.
Эти слова стали отражением его жизненной позиции: даже после десятилетий работы он смотрел вперед и мечтал о новых прорывах. Сегодня можно с уверенностью сказать, что именно благодаря Мешуламу исследования каннабиса превратились из маргинальной темы в одно из самых перспективных направлений современной науки. Его наследие продолжает жить, а его идеи и открытия еще долгие годы будут формировать медицину будущего.
Сорта конопли с медицинским эффектом
История исследований Рафаэля Мешулама убедительно показывает: каннабис — это не просто растение с древней культурной традицией, а источник соединений, которые способны менять медицину будущего. Благодаря его труду человечество узнало о ТГК, КБД, эндоканнабиноидной системе и уникальных каннабиноидных кислотах, каждая из которых по-своему влияет на организм. Его открытия дали импульс для разработки новых терапий и вдохновили ученых искать лекарственный потенциал в самом растении. Именно в этом контексте особенно интересно рассмотреть современные сорта каннабиса, обладающие выраженными медицинскими свойствами. В отличие от рекреационного использования, где главная цель — получить эффект от ТГК, в медицине ценится баланс каннабиноидов и терпенов, способный облегчать боль, снижать воспаление, стабилизировать настроение и поддерживать работу нервной системы.Ниже представлены три сорта, которые привлекли внимание исследователей и пациентов благодаря своему терапевтическому потенциалу. Каждый из них по-своему отражает ту самую идею Мешулама, согласно которой в каннабисе скрыт целый арсенал возможностей для здоровья, которые только начинают раскрываться.
Сорт конопли CBD Lemon Auto от Herbies Seeds
Сорт конопли CBD Lemon Auto из коллекции именитого испанского сидбанка Herbies Seeds, как и все творения этой компании, быстро покорил садоводов своим ярким внешним видом и невероятной смолистостью. Однако, кроме этого, он также может похвастаться коротким жизненным циклом длиной в 70-75 дней и высоким медицинским потенциалом. По ходу выращивания он непременно порадует гровера устойчивостью к самым разным угрозам, отличной реакцией на низкострессовые методы тренировок и неприхотливым характером, не требующим какого-то особого и постоянного ухода от своего владельца. Дегустация готового продукта сопровождается не только приятным ароматом восточных пряностей и сладким цитрусовым вкусом, но и целебным воздействием, успокаивающим сознание и тело, помогая насладиться моментом и избавиться от огромного числа недугов.
Сорт каннабиса Honeybells CBD от Delicious Seeds

Урожайность: 500 г/м2; 900 г/куст
Период цветения: 55-60 дней
Содержание ТГК и КБД: 7-10 % и 7-14 %
Сорт конопли Honeybells CBD от испанцев из Delicious Seeds представляет собой результат слияния генетик Caramelo и Karmen. Первая является сатива-доминантным гибридом с богатым терпеновым профилем и стойким иммунитетом, а вторая отличается терапевтическими свойствами. Все их достоинства благополучно перекочевали в преемника, который без проблем растет даже в не самых благоприятных условиях. Он проходит стадию цветения примерно за 55-60 дней, успевая сформировать большое количество отборных шишек, пропитанных густой смолой чудесным ароматом цитрусовых фруктов. Иногда запах может быть настолько сильным, что без угольного фильтра будет очень трудно обойтись. После сбора урожая, сушки и пролечки вы наконец сможете насладиться дегустацией в компании легкого расслабляющего эффекта, снимающего боль, усталость и нервное напряжение.
Сорт марихуаны Auto CBD-Victory от Dutch Passion

Урожайность: 400-500 г/м2; 50-150 г/куст
Жизненный цикл: 70 дней
Содержание ТГК и КБД: 0.3 % и 4-6 %
Сорт конопли Auto CBD-Victory стал новым словом в области медицинского каннабиса. Он был создан селекционерами голландской компании Dutch Passion путем тщательной и выверенной селекции. Они смогли добиться впечатляющих результатов, наделив свое творение минимальным уровнем содержания ТГК и достаточно высоким показателем КБД. Кроме того, готовый продукт сорта может похвастаться богатой вкусоароматической палитрой, состоящей из ноток сосны и сладких тропических фруктов. Автоцвет проходит все стадии роста примерно за 70 дней, принося 400-500 грамм урожая с квадратного метра в закрытом грунте и 50-150 грамм с куста на открытом воздухе. Эффект приятно удивит вас отсутствием психоактивности, вместо которой ситуацию берет под контроль приятное расслабление, подходящее для спокойного отдыха, а также снятия ментального и телесного напряжения.
Последнее редактирование модератором:

Информация в статье обновлена
Информация в статье обновлена